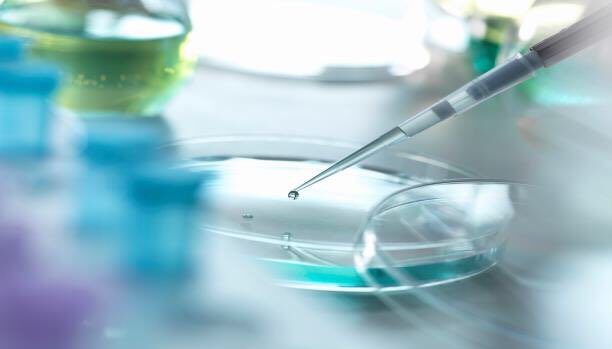

بنوك الأسنان:
(التجارة القادمة: وديعتك فيها هي الرابحة بإذن الله)
موضوع جديد نتكلم عنه في هذه السلسلة هاليومين بإذن الله
toothbank.com
(التجارة القادمة: وديعتك فيها هي الرابحة بإذن الله)
موضوع جديد نتكلم عنه في هذه السلسلة هاليومين بإذن الله
toothbank.com
٣- علاج واعد لمرض السكري لقدرة الخلايا الجذعية للتحول الى خلايا بنكارياسية جديدة..
وشلون يعني؟
رح اشرح شي مبسط عن تكوين العظم (مثلا) من الخلايا الجذعية من عصب السن 🦷 في التغريدة الأخيرة
وشلون يعني؟
رح اشرح شي مبسط عن تكوين العظم (مثلا) من الخلايا الجذعية من عصب السن 🦷 في التغريدة الأخيرة
جاري تحميل الاقتراحات...